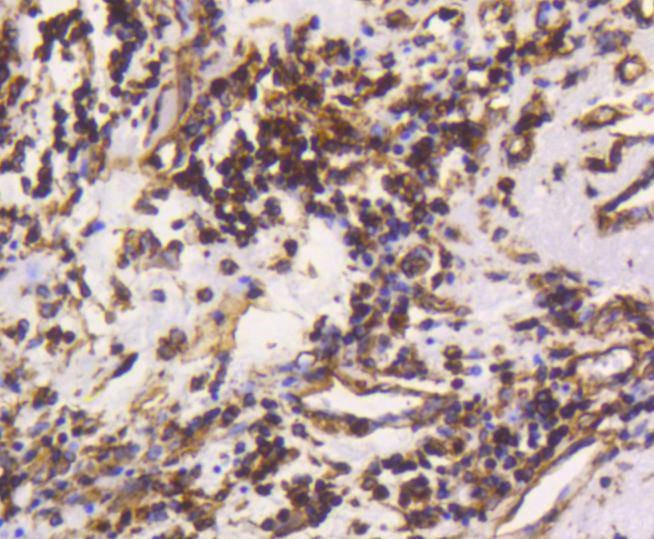
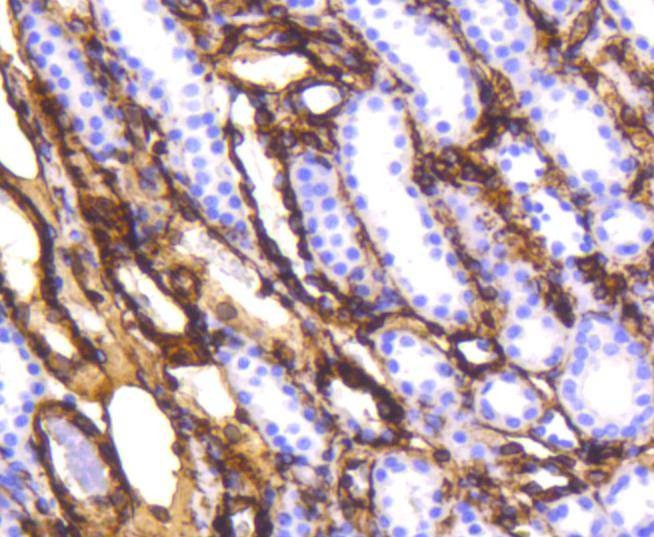

购物车
 您的购物车当前为空
您的购物车当前为空
Anti-Vimentin Antibody (3N67) 是一种 Rabbit 抗体,靶向 Vimentin。Anti-Vimentin Antibody (3N67) 可用于 FCM,ICC/IF,IHC,IP,WB。
别名 vimentin, HEL113, CTRCT30
Anti-Vimentin Antibody (3N67) 是一种 Rabbit 抗体,靶向 Vimentin。Anti-Vimentin Antibody (3N67) 可用于 FCM,ICC/IF,IHC,IP,WB。
| 规格 | 价格 | 库存 | 数量 |
|---|---|---|---|
| 50 μL | ¥ 1,490 | 5日内发货 | |
| 100 μL | ¥ 2,490 | 5日内发货 |
TargetMol的所有产品仅用作科学研究或药证申报,不能被用于人体,我们不向个人提供产品和服务。请您遵守承诺用途,不得违反法律法规规定用于任何其他用途。
| 产品描述 | Anti-Vimentin Antibody (3N67) is a Rabbit antibody targeting Vimentin. Anti-Vimentin Antibody (3N67) can be used in FCM,ICC/IF,IHC,IP,WB. |
| 别名 | vimentin, HEL113, CTRCT30 |
| Ig Type | IgG |
| 克隆号 | 3N67 |
| 反应种属 | Human,Mouse,Rat |
| 验证活性 | 1. Western blot analysis of Vimentin on different lysates using anti-Vimentin antibody at 1/1,000 dilution. Positive control: Lane 1: Hela, Lane 2: A549. 2. Immunohistochemical analysis of paraffin-embedded human breast carcinoma tissue using anti-Vimentin antibody. Counter stained with hematoxylin. 3. Immunohistochemical analysis of paraffin-embedded human kidney tissue using anti-Vimentin antibody. Counter stained with hematoxylin. 4. Immunohistochemical analysis of paraffin-embedded mouse colon tissue using anti-Vimentin antibody. Counter stained with hematoxylin. 5. Immunohistochemical analysis of paraffin-embedded mouse kidney tissue using anti-Vimentin antibody. Counter stained with hematoxylin. 6. ICC staining Vimentin in Hela cells (green). The nuclear counter stain is DAPI (blue). Cells were fixed in paraformaldehyde, permeabilised with 0.25% Triton X100/PBS. 7. ICC staining Vimentin in L6 cells (green). The nuclear counter stain is DAPI (blue). Cells were fixed in paraformaldehyde, permeabilised with 0.25% Triton X100/PBS. 8. ICC staining Vimentin in C2C12 cells (green). The nuclear counter stain is DAPI (blue). Cells were fixed in paraformaldehyde, permeabilised with 0.25% Triton X100/PBS. 9. ICC staining Vimentin in 293 cells (green). The nuclear counter stain is DAPI (blue). Cells were fixed in paraformaldehyde, permeabilised with 0.25% Triton X100/PBS. 10. Flow cytometric analysis of Hela cells with Vimentin antibody at 1/50 dilution (red) compared with an unlabelled control (cells without incubation with primary antibody; black). Alexa Fluor 488-conjugated goat anti rabbit IgG was used as the second antibody. |
| 应用 | FCMICC/IFIHCIPWB |
| 推荐剂量 | WB: 1:1000-5000; IHC: 1:100-500; ICC/IF: 1:100-500; FCM: 1:50-100 |
| 抗体种类 | Monoclonal |
| 宿主来源 | Rabbit |
| 构建方式 | Recombinant Antibody |
| 纯化方式 | ProA affinity purified |
| 性状 | Liquid |
| 缓冲液 | 1*TBS (pH7.4), 1%BSA, 40%Glycerol. Preservative: 0.05% Sodium Azide. |
| 研究背景 | Cytoskeletal intermediate filaments (IFs) constitute a diverse group of proteins that are expressed in a highly tissue-specific manner. Intermediate filaments are constructed from two-chain, a-helical, coiled-coil molecules arranged on an imperfect helical lattice and have been widely used as markers for distinguishing individual cell types within a tissue and identifying the origins of metastatic tumors. One such intermediate filament protein, Vimentin, is a general marker of cells originating in the mesenchyme. Vimentin is frequently coexpressed with other members of the intermediate filament family, such as the cytokeratins, in neoplasms including melanoma and breast carcinoma. |
| 偶联 | Unconjugated |
| 免疫原 | Recombinant Protein |
| Uniprot ID |
| 分子量 | Theoretical: 54 kDa. |
| 储存方式 | Store at -20°C or -80°C for 12 months. Avoid repeated freeze-thaw cycles. |
| 运输方式 | Shipping with blue ice. |